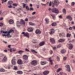

(17 de abril del 2023. El Venezolano).- Este domingo falleció el reconocido periodista Rodolfo Schmidt, destacado por su amplia trayectoria en las fuentes de economía y política en medios nacionales.
La noticia la dio a conocer su esposa, la también periodista Janeth Yucra, a través de su cuenta de Twitter, quien indicó que «««Mi esposo Rodolfo Schmidt nos dejó este domingo. Ya descansa y está en «la tasca Celestial», donde él decía que estaban sus amigos. Nos dejó un grande del periodismo, un caballero».
Schmidt, quien tenía varios días hospitalizado en el Hospital Vargas de Caracas, falleció a causa de un paro cardíaco debido a complicaciones respiratorias.
El Nacional reseñó que la familia del exdirector del extinto Diario de Caracas, Economía Hoy y diario Reporte de La Economía, había recurrido a la solidaridad de los ciudadanos que le conocieron a través de las redes sociales para cubrir los gastos médicos de su hospitalización, debido a la crisis económica que atraviesa el país.